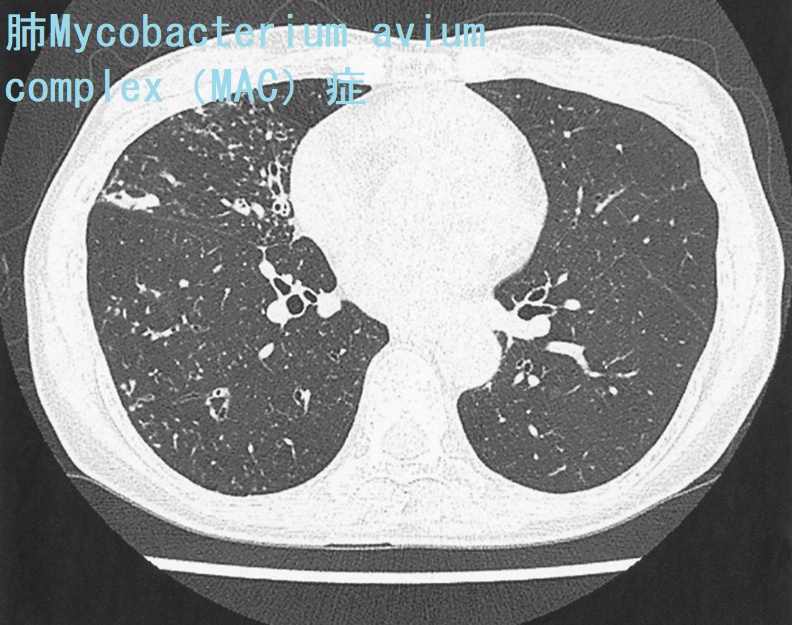
肺Mycobacterium avium complex(MAC)症 胸部単純CT 肺Mycobacterium avium complex(MAC)症 胸部単純CT

甲状腺/糖尿病と免疫不全・細菌、日和見感染①[日本甲状腺学会認定 甲状腺専門医 橋本病 バセドウ病 甲状腺エコー 長崎甲状腺クリニック 大阪]
長崎甲状腺クリニック(大阪)は甲状腺専門クリニックに特化するため、糖尿病内科を廃止しました。
また、長崎甲状腺クリニック(大阪)は感染症の診療を行っておりません。
糖尿病:専門の検査治療[橋本病 バセドウ病 甲状腺超音波エコー 長崎甲状腺クリニック大阪]
甲状腺専門・内分泌代謝・動脈硬化の長崎甲状腺クリニック(大阪府大阪市東住吉区)院長が海外・国内論文に眼を通して得た知見、院長自身が大阪市立大学(現、大阪公立大学) 代謝内分泌内科で得た知識・経験・行った研究、甲状腺学会で入手した知見です。
長崎甲状腺クリニック(大阪)以外の写真・図表はPubMed等において学術目的で使用可能なもの(Creative Commons License)、public health目的で官公庁・非営利団体等が公表したものを一部改変しています。引用元に感謝いたします。尚、本ページは長崎甲状腺クリニック(大阪)の経費で非営利的に運営されており、広告収入は一切得ておりません。
甲状腺・動脈硬化・内分泌代謝・糖尿病に御用の方は 甲状腺編 動脈硬化編 甲状腺以外のホルモンの病気(副甲状腺/副腎/下垂体/妊娠・不妊など) 糖尿病編 をクリックください
Summary
甲状腺機能低下症と糖尿病は免疫不全で日和見感染や感染症の重症化がおこる。非定型抗酸菌、緑膿菌、ストレプトコッカスアガラクティエ(B群溶血性連鎖球菌の一種)で急性化膿性甲状腺炎。マイコバクテリウム・マリナムは最多の非定型抗酸菌感染症で熱帯魚や水槽から感染。無顆粒球症では緑膿菌(Pseudomonas aeruginosa)敗血症。レジオネラ菌はエアコン・加湿器(特に家庭用超音波式加湿器)・水場・循環式風呂/温泉が感染源になり集団感染。レジオネラ肺炎は大葉性肺炎。ストレプトコッカスアガラクティエは新生児髄膜炎、子宮内感染、敗血症/内因性眼内炎、感染性心内膜炎。
Keywords
甲状腺,甲状腺機能低下症,糖尿病,免疫不全,日和見感染,感染症,急性化膿性甲状腺炎,緑膿菌,レジオネラ肺炎,非定型抗酸菌
甲状腺と糖尿病
1型、2型糖尿病を問わず甲状腺疾患の合併が多いとされます[BMC Med. 2016 Sep 30; 14(1):150.][Clin Endocrinol (Oxf). 2011 Jul;75(1):1-9.]。詳しくは 甲状腺と糖尿病 を御覧下さい
甲状腺機能低下症と免疫力低下には、いろいろな意見があります。甲状腺ホルモンの低下そのものが、免疫系統に直接影響する証拠はありません。[ただし、最近の基礎医学研究では、甲状腺ホルモンそのものが免疫系の細胞に作用し、活性化させる研究結果が大半を占め、感染防御に大きな役割を担う可能性があります(甲状腺と自然免疫 )。]
甲状腺機能が低下した状態では、全身の新陳代謝低下と、低体温による2次的な免疫不全が存在します。
例え、甲状腺機能低下症の方でも、甲状腺ホルモン剤(チラーヂンS)で血中甲状腺ホルモン濃度を正常範囲にコントロールすれば、正常な人と同じ免疫力になります。
しかしながら、甲状腺機能低下症が見逃されたり、甲状腺機能低下症と診断されても患者自身が治療を放棄、あるいは甲状腺ホルモン剤(チラーヂンS)補充を開始して間がなく、血中甲状腺ホルモン濃度が正常範囲に到達していない状態では免疫不全の状態です。(第58回 日本甲状腺学会 P2-10-6 急速に進行した甲状腺機能低下症にRamsay Hunt症候群を認めた83歳女性の一例)
糖尿病の高血糖下では免疫細胞の働きが妨げられ、免疫不全状態にあります。感染症を起こしやすくなり、通常なら感染しないような弱毒菌に感染する日和見感染をおこします。また、体内で発生した癌細胞を駆除できず、癌が進行します、
- 肺炎球菌
- 急性化膿性甲状腺炎
- 過去の病気ではない結核
- 結核と似ているけど違う非定型抗酸菌症(非結核性抗酸菌症)
- 肺ノカルジア症/脳ノカルジア症
- レジオネラ肺炎:糖尿病の方の温泉旅行や加湿器は要注意
- 緑膿菌
- 糖尿病妊婦の眼にも来る!感染性心内膜炎も。ストレプトコッカス・アガラクチア
- 院内肺炎
甲状腺/糖尿病と免疫不全・細菌、日和見感染②
- バンコマイシン耐性腸球菌(糖尿病の危険な感染性心内膜炎)
- 伝染性膿痂疹または膿痂疹(とびひ)
- 市中感染型MRSA (どこにでもいる抗生剤耐性菌、糖尿病の人は要注意)
- モラクセラ・カタラーリス(ブランハメラ・カタラーリス)
- ヘリコバクターシネジー
- 高アンモニア血症による意識障害をきたす尿路感染コリネバクテリウム・ウレアリティクム
- 化膿性脊椎炎
- 多剤耐性アシネトバクター
- 糖尿病のひとはネコに引っ搔かれないように!ねこひっかき病
- 侵襲性インフルエンザ桿菌感染症
- 慢性疲労症候群?Q熱
- 高齢糖尿病で気腫性胆嚢炎
- 長引く咳、甲状腺じゃなくて百日咳
食中毒菌と甲状腺、糖尿病
急性化膿性甲状腺炎
「結核菌」「ライ菌」以外の抗酸菌は「非定型抗酸菌(非結核性抗酸菌)」です。自然界に広く存在し、甲状腺機能低下症や糖尿病他免疫不全者に感染します[Infect Chemother. 2017 Nov 8;50(1):59–64.]が、人から人への感染はなく、隔離の必要はありません。
非定型抗酸菌症(非結核性抗酸菌症)は増加傾向です。肺Mycobacterium avium complex(MAC)症は、特に患者数が急増しており、結核死亡者数を超えているともされます。
非定型抗酸菌症は男性35%、女性65%、いずれも70歳代の高齢者に多い。
Mycobacterium avium complex(MAC)が約9割で最も多く、Mycobacterium kansasii、Mycobacterium abscessusがみられる。Mycobacterium kansasii、MAC、Mycobacterium intracellulareは遅速発育菌ですが、最近は難治性の迅速発育菌(M.abscessus)が増加傾向です。
遅速発育菌は寛解増悪の自然経過をとり、微熱、断続的な血痰などを繰り返します。
肺CTの線維空洞・小結節/浸潤性(円筒状)気管支拡張陰影(signet rng sign, tram line, tree in bud pattern)は非定型抗酸菌を疑う所見ですが、実際、細菌性の方が多い。空洞があると予後は悪くなります。
肺非結核性抗酸菌症の診断は、
- 喀痰抗酸菌培養検査(菌種同定を行うことにより、確定診断が得られる。自然界のものが混じるため、必ず2回以上行う)
- M.avium、M.intracellulare PCRも併用
- 痰が出ない場合や診断が難しい場合、気管支肺胞洗浄液で培養されれば確実性が高い
最近開発されたキャピリアMAC抗体(抗酸菌抗体定性)は感度70%・特異度90%(アビウム、イントラセルラーレ合わせてMAC:全体の70%)で有用。MAC抗体(抗酸菌抗体定性)は過去の非定型抗酸菌(非結核性抗酸菌)曝露によっても陽性になるので、現在の活動性を反映しません。
肺非結核性抗酸菌症は診断確定しても、必ずしも全員に治療を行う訳ではありません。空洞、塗抹陽性、血痰・喀血などがあれば積極的に治療を考慮する。
高齢者や結節性気管支拡張だけでは、経過観察になる事が多い。
多くの抗菌薬に自然耐性があるため、薬が効きにくい。治療はクラリスロマイシン+抗結核薬2 剤(リファンピシン・エタンブトール)の3 剤併用療法が基本ですが、多くは治療抵抗性。リファンピシンは薬剤性甲状腺機能低下症の原因です。
非定型抗酸菌の1.8%に肺癌を合併するとされ、注意を要します。
72歳のインスリン依存性糖尿病+甲状腺機能低下症/橋本病患者におきたMycobacterium avium intracellulareを起因菌とする急性化膿性甲状腺炎の報告があります[J Endocrinol Invest. 1994 Feb;17(2):133-4.]
皮膚の非結核性抗酸菌症(非定型抗酸菌症)マイコバクテリウム・マリナム(M.marinum)感染症
マイコバクテリウム・マリナム(Mycobacterium marinum)感染症は、皮膚の非結核性抗酸菌症(非定型抗酸菌症)の中で最も頻度が高い。熱帯魚などの魚、水槽、魚介類の入ったクーラーボックス、プールの水などから感染するため、魚を扱う仕事の人・水族館の飼育員に多い。
マイコバクテリウム・マリナム(Mycobacterium marinum) は体温よりも低い環境で増殖するため、手指~前腕に好発。低体温になる甲状腺機能低下症患者では要注意。
手先→前腕に架けて発赤を伴う結節が多発し、表面は一部びらん、痂皮、膿疱を伴うが、局所熱感と圧痛とを認めない。
病変部の膿汁にZiehl-Neelsen 染色陽性菌を認める。皮膚生検では類上皮細胞肉芽腫と非特異的炎症像が混在し、サルコイドーシスとの鑑別要。小川培地で7 週後に白色コロニーを形成。
治療はテトラサイクリン系抗菌薬(ミノサイクリンまたはドキシサイクリン)またはマクロライド系抗生物質を3-6か月投与。
レジオネラ肺炎とは
レジオネラ菌は水場を好むため、エアコン・加湿器(特に家庭用超音波式加湿器)・うがいの行列ができる水場・循環式風呂/温泉、貯めていた雨水が感染源になります。実際、スーパー銭湯や大浴場で集団感染(アウトブレイク)が起こり、死亡者が出た事件もありました。また、井戸水を使用したり、貯めていた雨水で庭に水をまいたりして感染する例もあります。
レジオネラ肺炎は届出義務のある4類感染症です。非定型肺炎ですが、免疫抑制剤・副腎皮質ステロイド剤投与中の関節リウマチや糖尿病の免疫不全患者で劇症肺炎化(大葉性肺炎)し、横紋筋融解症も引きおこします[(甲状腺機能亢進症/バセドウ病,甲状腺機能低下症/橋本病の様)]。[Clin Case Rep. 2024 Mar 7;12(3):e8628.][Respir Med Case Rep. 2020 Dec 9;32:101321.]
レジオネラ症における横紋筋融解症の作用機序は不明ですが、
- レジオネラ菌が筋肉へ直接侵入
- エンドトキシンによる筋肉の損傷
が考えられています[South Med J. 1984 Jun;77(6):777-9.]。
レジオネラ肺炎では、
- SIADH(抗利尿ホルモン不適合分泌症候群)による低ナトリウム(Na)血症(約46%)[BMC Infect Dis. 2013 Dec 11:13:585.]
- 低リン血症;近位尿細管障害の可能性
- 中枢神経症状;頭痛、意識障害からけいれん(甲状腺クリーゼ/粘液水腫性昏睡の様)、(甲状腺機能亢進症/バセドウ病の様)
も起こります。
喀痰グラム染色で多核好中球を多数認めても、明らかな原因菌は確認できません(レジオネラは細胞内寄生菌のため)。
以前はレジオネラ菌の培養同定に数日を要し、その間にレジオネラ肺炎が悪化していましたが、現在は尿中レジオネラ抗原検査が可能になり、3時間で迅速に診断できます。ただし、尿中レジオネラ抗原検査キットは70%しか陽性になりません。
レジオネラ肺炎の胸部CTは特徴的な「広範に広がるすりガラス陰影内に,区域性/亜区域性の気管支血管束周囲の斑状浸潤陰影」。実際の写真を見た方が解り易いです。
レジオネラは細胞内寄生細菌で、宿主細胞に浸透する
- ニューキノロン系;ニューキノロン剤の静脈投与が第一選択
- マクロライド系(エリスロマイシンなど)+リファンピシン
の抗生剤を使用。リファンピシンは薬剤性甲状腺機能低下症の原因になります。
セフェム系、カルバペネム系抗生剤は細胞内移行が悪く、ほとんど無効。
加湿器でレジオネラ菌の院内感染が!?
加湿器の水槽水は、緑膿菌、アシネトバクター、レジオネラなどの菌で汚染され、院内感染の原因となります。そのため、病室での加湿器の使用を禁止している医療機関が主流です。待合室で加湿器を使用するのは、いかがなものかと思います。加湿器には蒸気式(スチーム式、スチームファン式)、フィルター気化式(ヒーターレスファン式)、超音波式などの種類があり、超音波式は、微生物で汚染された水槽の水から、微生物含有のエアロゾルが大量に噴出されるため、医療環境では使用しないよう勧告されています。超音波式以外の加湿器でも、定期的な水槽の洗浄やフィルター交換が必要です(気化式の一部には、少量ながら汚染菌が排出される構造の機器もあり)。(鹿児島大学大学院医歯学総合研究科 微生物学分野の鹿児島ICTネットワークより)
(朝日新聞デジタルより)
緑膿菌はムコイド産生型のグラム陰性桿菌で、医療・介護関連肺炎(NHCAP:nursing and health-care associated pneumonia)の起因菌でもある。Klebsiella pneumoniae(クレブシエラ・ニューモニエ、肺炎桿菌もムコイド産生型のグラム陰性桿菌であるが、微妙に形状が異なる。

甲状腺機能亢進症/バセドウ病治療に用いる抗甲状腺薬(メルカゾール、プロパジール、チウラジール)の最も恐ろしい副作用の一つが無顆粒球症です。無顆粒球症では緑膿菌(Pseudomonas aeruginosa )による敗血症を合併しやすい(無顆粒球症と緑膿菌感染 )[QJM. 1999 Aug;92(8):455-61.]。
甲状腺亜全摘術後に再発した甲状腺機能亢進症/バセドウ病女性で頬と脚の壊疽性潰瘍・蜂窩織炎(緑膿菌壊疽)をおこした報告があります[Int J Infect Dis. 2014 Apr;21:19-20.]。
緑膿菌による急性化膿性甲状腺炎の報告があります[Br Med J. 1977 Aug 27;2(6086):580.]。
緑膿菌は水場を好む菌です。緑膿菌毛包炎は、特殊な毛包炎で温水プール(循環式浴槽)、銭湯、プールのすべり台、サウナ、洗面台のスポンジ、ウェットスーツなどで感染します。
家族内感染をおこす事もあります。
普通の毛包炎は通常、表皮ブドウ球菌、黄色ブドウ球菌が原因です。緑膿菌性毛包炎は通常の毛包炎より痒み、痛みは強いが、見た目は同じで、緑色膿と違います。
第3世代セフェム、ニューキノロン系抗生物質内服、アミノグリコシド、ニューキノロン系抗生物質軟膏が有効。
免疫能が低下した場合、壊疽性膿瘍・緑膿菌壊疽(壊疽性膿皮症とは異なる)に進展することがあります。
悪性外耳炎
悪性外耳炎(malignant external otitis)は、名前が悪性になっていますが悪性腫瘍ではありません。周囲組織を破壊(外耳道骨破壊)しながら急激に進行し、致命的になり得るため、悪性外耳炎と呼ばれます。
悪性外耳炎は、高齢者、糖尿病(約80%)、透析患者など免疫不全患者に発症し、起因菌は緑膿菌やMRSAが多い。悪性外耳炎の治療は、局所の洗浄・デブリードマンと抗生物質投与。手術になる場合も。
[Arq Neuropsiquiatr. 1985 Dec;43(4):384-90.]
ストレプトコッカス・アガラクチア(ストレプトコッカスアガラクティエ、Streptococcus agalactiae)はGBS【B群溶血性連鎖球菌】の一種です。
糖尿病患者では膿瘍、蜂窩織炎、糖尿病壊疽の原因になります。
産道感染による新生児髄膜炎が有名です。糖尿病妊婦では子宮内への上行性感染で早産・早期破水・絨毛羊膜炎(38度以上の発熱、早産の原因)・産褥期敗血症を、糖尿病男性では前立腺炎があります。
妊娠末期(35~37週)の腟分泌物細菌培養検査でB 群連鎖球菌(GBS)が陽性となった妊婦には、母子感染予防対策として、陣痛開始時(分娩の4時間以上前)にペニシリン系抗菌薬投与を開始。
糖尿病の免疫不全では敗血症/内因性眼内炎による失明、感染性心内膜炎が報告されます。糖尿病性感染性心内膜炎はストレプトコッカス・アガラクチアがもっとも多いとの報告があります。
ストレプトコッカスアガラクティエによる急性化膿性甲状腺炎の報告があります[Clin Case Rep. 2017 Jun 19;5(8):1238-1242.]
甲状腺関連の上記以外の検査・治療 長崎甲状腺クリニック(大阪)
- 甲状腺編
- 甲状腺編 part2
- 内分泌代謝(副甲状腺/副腎/下垂体/妊娠・不妊等
も御覧ください
長崎甲状腺クリニック(大阪)とは
長崎甲状腺クリニック(大阪)は日本甲状腺学会認定 甲状腺専門医[橋本病,バセドウ病,甲状腺超音波(エコー)検査など]による甲状腺専門クリニック。大阪府大阪市東住吉区にあります。平野区,住吉区,阿倍野区,住之江区,松原市,堺市,羽曳野市,八尾市,天王寺区,東大阪市,生野区,浪速区も近く。